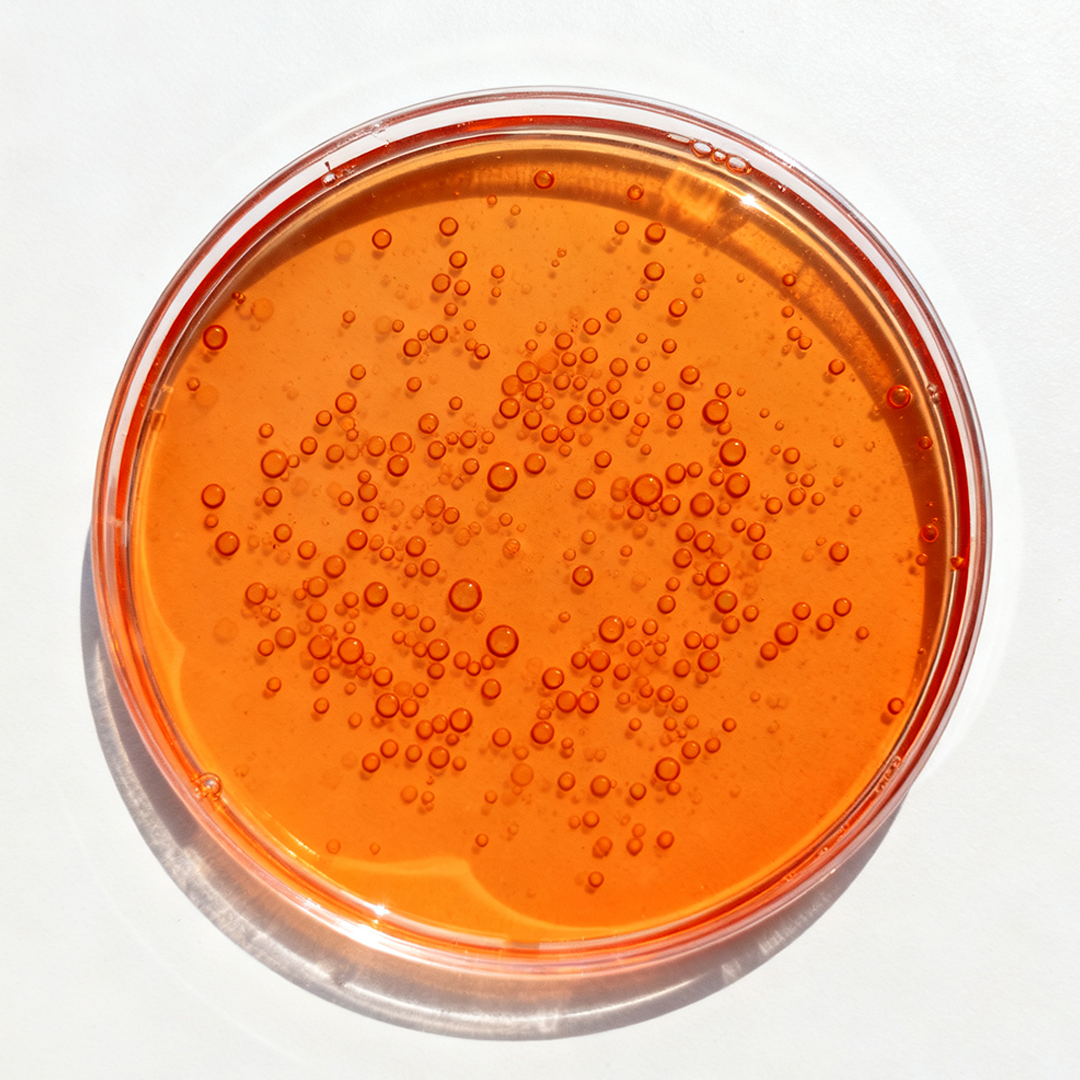

Ingredients
Discover style insights and trends on our fashion lifestyle blog.
Vitamin C
Targeted Skin Concerns· Dull or Tired-Looking Skin· Uneven Complexion· Lack of Radiance How It Appears on Ingredient ListsCommonly listed as Ascorbic Acid — the...
Oct 09 2025
Retinol
Targeted Skin Concerns· Fine Lines & Wrinkles· Dull, Tired-Looking Skin· Uneven Tone How It Appears on LabelsSimply listed as Retinol — the purest and...
Oct 09 2025
Peptides
Targeted Skin Concerns· Fine Lines & Wrinkles· Loss of Firmness How They Appear on Ingredient LabelsLook for names such as acetyl hexapeptide, acetyl octapeptide,...
Oct 09 2025
Glycerin
Skin Concerns· Dryness· Early fine lines What You’ll Find in the FormulaGlycerin Why It Matters for Your SkinGlycerin is a deeply hydrating ingredient that...
Sep 18 2025